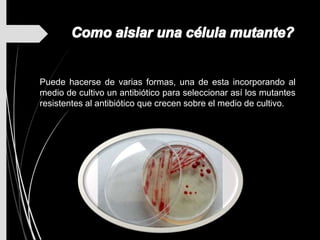
Puede hacerse de varias formas, una de esta incorporando al
medio de cultivo un antibiótico para seleccionar así los mutantes
resistentes al antibiótico que crecen sobre el medio de cultivo.
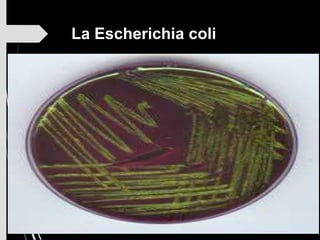
La Escherichia coli

Este documento trata sobre genética bacteriana. Explica que la genética bacteriana estudia el material genético de las bacterias, el cual se encuentra principalmente en un cromosoma circular de ADN. También contiene información sobre cómo ocurren variaciones genéticas en las bacterias a través de mutaciones y recombinación genética, así como sobre el código genético universal y sus características.